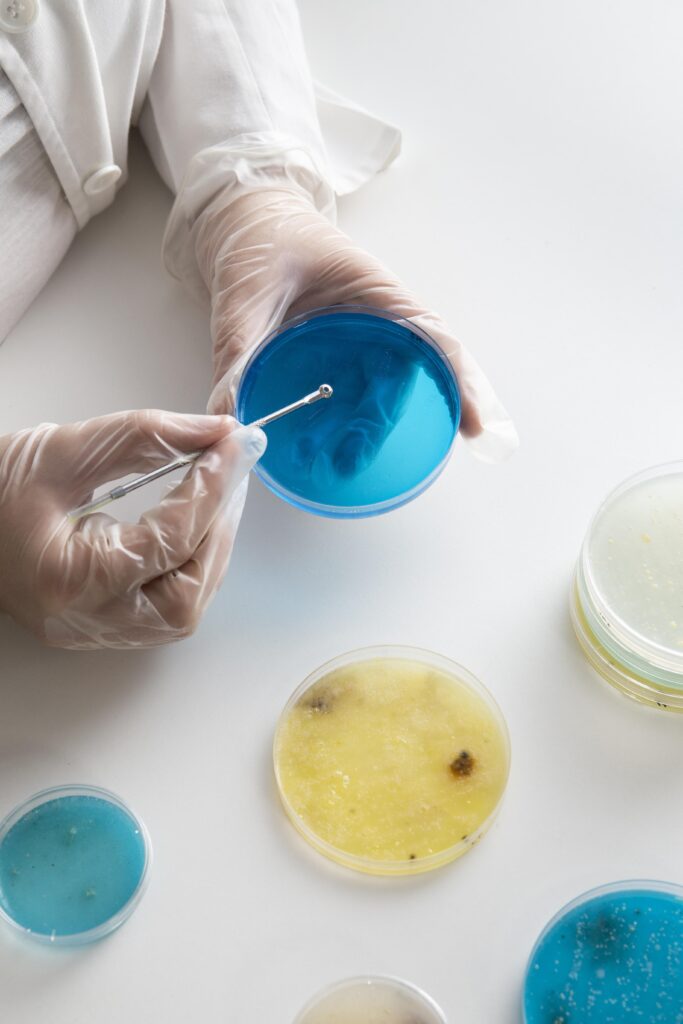

Esami Micologici
Presso ConiZugnaMedica è possibile effettuare l’esame micologico colturale su cute o unghie per confermare o escludere il sospetto di micosi cutanea o di onicomicosi.
Verranno prelevate squame di cute o piccoli frammenti di unghia su cui verrà effettuata la ricerca dei miceti.
Ai fini dell’attendibilità dell’esito dell’esame, si richiede di NON utilizzare creme, smalti o altri prodotti antimicotici e di limitare anche antisettici e, in generale, l’applicazione di creme nella sede del prelievo nella settimana precedente la raccolta del campione.
L’esame può essere effettuato sia a seguito di una visita dermatologica presso la nostra struttura, sia in caso di prescrizione da parte di un dermatologo o altro clinico esterno cui si verrà reindirizzati per la valutazione dell’esito e le eventuali indicazioni terapeutiche conseguenti.